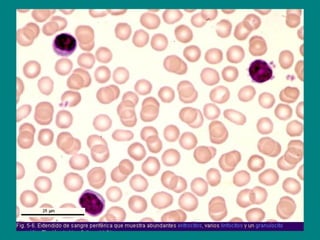
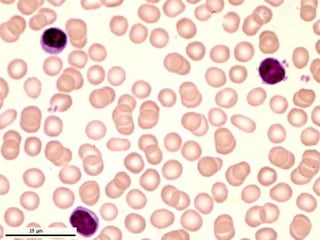
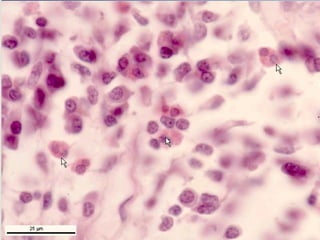
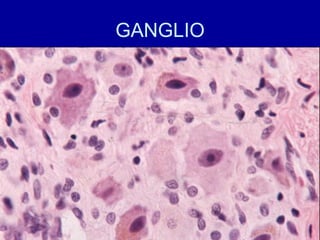
GANGLIO
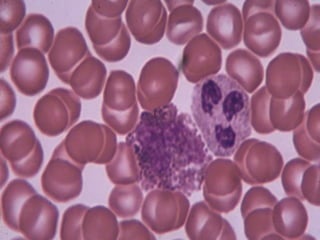
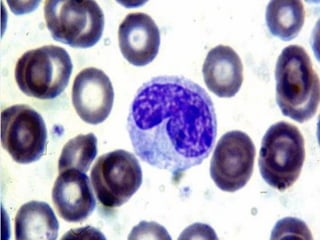
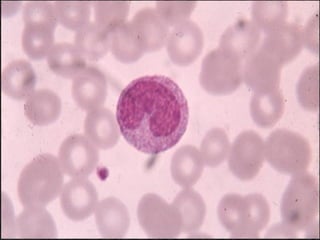
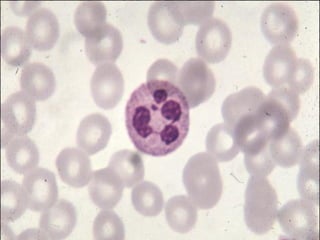
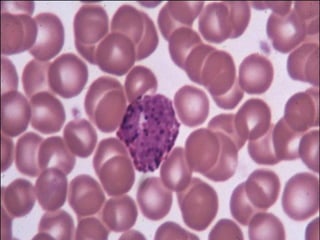
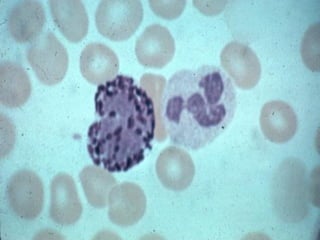
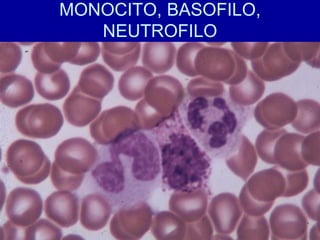
MONOCITO, BASOFILO,
NEUTROFILO
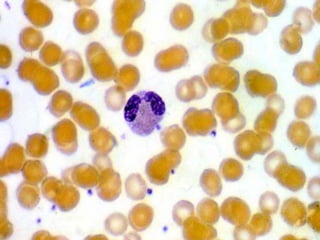
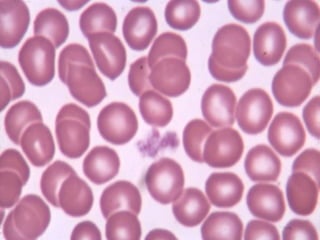
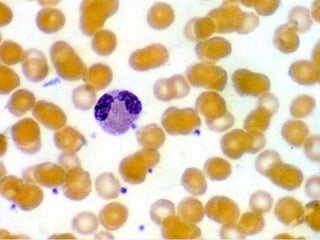
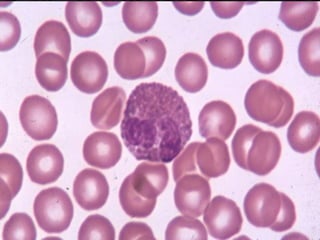
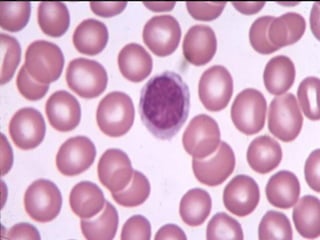
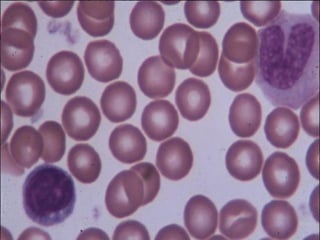
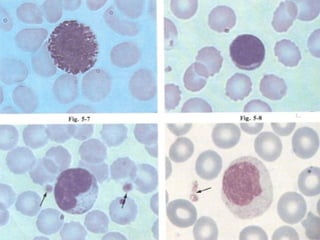

El documento detalla los métodos de preparación de tejidos para su observación, dividiéndolos en técnicas para células vivas y muertas, incluyendo el cultivo de tejidos, microdisección y tinciones. También se describe el proceso de preparación histológica, que consiste en fijación, inclusión, corte, tinción y montaje, así como la clasificación de los epitelios y su regeneración. Se abordan los artefactos que pueden surgir durante la preparación y los tipos de tejido epitelial, incluyendo sus características y funciones.